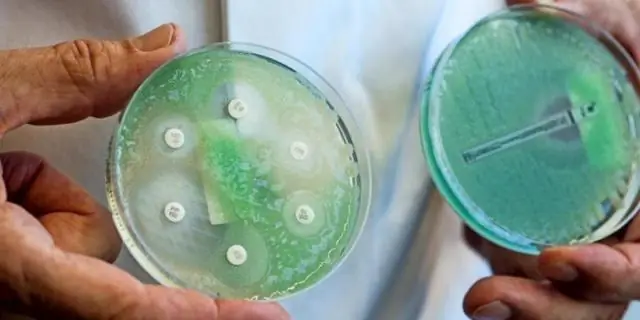
Исследователи нашли способ убить патоген, устойчивый к антибиотикам

Pseudomonas aeruginosa - опасная бактерия, вызывающая инфекции в больничных условиях и у людей с ослабленной иммунной системой. Это может вызвать заражение крови и пневмонию, а тяжелые инфекции могут быть смертельными. По данным Всемирной организации здравоохранения, P. aeruginosa, обладающая высокой устойчивостью к лечению антибиотиками, является одним из наиболее серьезных патогенов, срочно требующих альтернативных стратегий лечения.
Эта бактерия - одна из многих, которые развили систему, которая позволяет им получать труднодоступное железо из человеческого организма. Железо необходимо для роста и выживания бактерий, но у людей большая его часть удерживается в гемоглобиновом комплексе «гем». Чтобы заполучить его, P. aeruginosa и другие бактерии выделяют белок, называемый HasA, который прикрепляется к гему в крови. Этот комплекс распознается мембранным рецептором бактерии, называемым HasR, что позволяет гему проникнуть в бактериальную клетку, в то время как HasA повторно используется для захвата большего количества гема.
Бионеорганический химик Осами Сёдзи из Университета Нагоя и его сотрудники нашли способ использовать эту «систему получения гема» для доставки лекарств. Они разработали порошок, состоящий из HasA и пигмента фталоцианина галлия (GaPc), который при нанесении на культуру P. aeruginosa поглощался бактериями.
«Когда пигмент подвергается воздействию ближнего инфракрасного света, внутри бактериальных клеток образуются вредные активные формы кислорода», - объясняет Сёдзи. При тестировании более 99,99% бактерий были уничтожены после обработки одним микромоляром HasA с GaPc и десятью минутами облучения.
Эта стратегия также работала на других бактериях с рецептором HasR на их мембранах, но не на бактериях без него.
Система накопления гема настолько важна для выживания этих бактерий, что не ожидается, что она изменится, поэтому маловероятно, что у бактерий разовьется устойчивость к этой лекарственной стратегии, считают исследователи.
"Наши результаты подтверждают использование искусственных белков гема в качестве троянского коня для избирательной доставки противомикробных препаратов к бактериям-мишеням, обеспечивая их специфическую и эффективную стерилизацию, независимо от устойчивости к антибиотикам", - сообщает команда в своем исследовании.